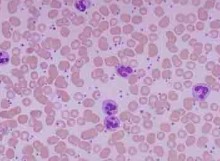
黏附

-

描写黏附的段落
滴水岩三面环山,又尽是悬崖峭壁。正面的景象则是它得名的来由:墙壁上,千百条大大小小、曲曲直直的树根上黏附满难以计数的水珠,仿佛是一串串用白玉和水晶做成的大玉珠,滴滴晶莹而圆滚的小水珠聚成涓涓细流,从树枝上流泻下来。又在岩石间的水洼中积聚,汇成一股股小溪,缓缓地流出山林。在这潺潺的流水声中,时而夹着声声蛙鼓,时而夹着声声鸟鸣,更为这洞天仙境增添无穷生机与情趣。
《美丽的滴水岩》的优美段落摘抄
描写黏附的段落
描写黏附的段落
滴水岩三面环山,又尽是悬崖峭壁。正面的景象则是它得名的来由:墙壁上,千百条大大小小、曲曲直直的树根上黏附满难以计数的水珠,仿佛是一串串用白玉和水晶做成的大玉珠,滴滴晶莹而圆滚的小水珠聚成涓涓细流,从树枝上流泻下来。又在岩石间的水洼中积聚,汇成一股股小溪,缓缓地流出山林。在这潺潺的流水声中,时而夹着声声蛙鼓,时而夹着声声鸟鸣,更为这洞天仙境增添无穷生机与情趣。
阳光似乎总是念恋那些木质的桌子,它们安静地黏附在上面,直到飞鸟飞回云层涅没,班主任也永远喜欢黏附在讲台上如同那些细碎的阳光,用他那略带嘶哑而又急促的声音告诉我们这群漫不经心的孩子中考是如何如何重要,生物地理在即将到来的中考中又是那样那样的重要。
山涧有一条小溪,清流见底,是不远处两眼清泉的交汇,水里黏附在石头上的青苔,随着水流的冲刷,向下游方向荡开。有时,翻开碎石砖瓦的下面,有巴掌大的小青蟹,半指长的小鱼从你手边飞快的游过。泉水淙淙,一切凡世的尘埃,都随清流远去,心中如明镜一般祥和、安定。大概,只有在这诗画一般的地方,才能给心里最美好的角落洒下一片绿荫吧!
植物的花有香味是为了传宗接代。植物花朵为了引诱昆虫前来授粉,不仅呈现各种艳丽夺目的色彩,还会散发各种迷人的花香。于是引来蜂蝶竞相采蜜,正所谓“蜂争粉蕊蝶分香”。结果,花粉黏附在昆虫的身上,随着昆虫的飞行迁移而四处落户安家了。
端坐六月的丁香树下,从繁华的山林里柔柔的吹度过来一股幽远的馨香,黏附一息温润滑腻的水气,把远方的思念如丝巾般轻轻、轻轻的摩挲在我的脸颊,低语呢喃的刹那,如花的往事被窗前的月光撩动,我循着紫色的暗香在夜色里落笔,任情思消散成六月花巷里的云卷云舒。
走到大门口总能看见一位老大爷,他两鬓斑白,虽有一丝丝银发,满脸的皱纹,但是精气神儿十分好,老当益壮,拿着扫把打扫着小区大门口。“这么大一个小区,您一个人怎么扫的完?”一个热心肠的阿姨问道,老人只是笑了笑,继续扫着。这使我想起了一首诗:扫地,扫地,扫心地……晚上,我放学回家,小区里一片喧闹声,看到我们楼道里,依旧是那位老爷爷在我们楼道里,擦着扶梯,只见扶梯上灰尘比蚂蚁还要密。我以前无聊时也擦过,但我擦得从没有那么认真仔细,只是作为一种娱乐罢了。他时而擦着厚厚的灰尘,时而走到水盆边洗着黏附了许多灰尘的毛巾。顿时,刚才还是尘土飞扬的楼道,现在已经一尘不染了。对于我们社会上来说,真正需要的就是像这位老爷爷一样的好心人。
步履匆匆,还来不及收拾一地残红的余馨,便早已黏附着鞋沿,和着春泥的乡土气息;一个脚印,便是一处馥郁与温情。毕竟,此庭不似彼庭,无“积水空明”的夜幕下的颜容,许是“暖风迟日也,已到杏花肥”,花朵儿在簇拥着的枝桠中彼此攒蹙,此起彼伏,竞争妍媸,再添上几色草绿的润笔,如此又哪知前头古人的足迹曾在这片熟悉的处女地“着了先鞭”了呢?而我所礼赞的东风是礼貌安葬西风的使者;纵使“西风烈,长空雁叫霜晨月”,萧瑟煞风景,终是难以彰显整个四季的精气神风貌的。东风,她么,先是含着珠泪徐徐而悄悄地播之在川泽原野,润泽了一方干涸的泥塘,销去了冰凝雪冻缠绕的盘桓死肌;她也是一位博爱高雅的母亲,孕育了剔透、玲珑的露珠儿;她更是以美声天籁赢取诗情畅想的诗坛乐界的骄子!“一曲东风一梦遥”,莫不是沉醉于东风的气氛中,浮游于太虚别境的“天外天”。试问:亦梦?试想:亦真?
等我们走到马路另一边,我再次看垃圾箱时,一位耳朵上挂着口罩,穿红背心制服的清洁工阿姨推着垃圾车缓缓走到了垃圾箱旁。清洁工阿姨瞧见了满地散发着臭味的垃圾,像是早已见惯似的,便把垃圾车停稳,把挂在一边的口罩戴好,又把大扫帚从垃圾车上拿下来,清理起了垃圾。阿姨熟练地挥动着扫帚,眼睛全神贯注地看着地面,手有节奏地一摆一摆,想把垃圾扫成一堆,可垃圾赖皮似的黏附在地上不肯动,还有些团在一起,竹制的扫帚根本不起作用。这该怎么办呢?我边慢慢走着边注视着她。阿姨把扫帚放在垃圾车旁靠好,拿起铲子铲起了垃圾,铲起一铲垃圾,就倒进垃圾车。这样的动作重复着……
风过,雨停,天地一片湿漉漉的绿意葱茏,水袖长衫的掩过高山,漫过水岸,在不远处的弄堂口里轻卷珠帘,放眼六月的花巷深处,立时有了一股古朴淡远的馨香之气,山为德,水为性的安坐于云雾山中辩经论道,回环在花为媒的柳巷里追古溯今,春夏交替的六月,嫣然一幅张大千临摹的水墨画,丝丝缕缕都黏附有田园风光的妖娆,小桥、流水、人家的往来穿梭在时光的织布机上,入诗、入画又魅力十足的刺绣着唐诗宋词里婉约的味道。
韩寒的七门功课亮红灯,但也能欣然地被复旦大学录取。这是多少莘莘学子梦寐以求的事啊!可是,韩寒却用他的自傲“横眉冷对”当今教育界。可能,韩寒只想像陶渊明那样,把开阔的哲学理念深藏于胸,挥去衣袖上黏附的世俗陈腐,去东篱下悠然采菊。在韩寒眼中重要的固然不是学习,而是随心所欲地挥洒青春的热情。或许就是这种性格,才使韩寒酝酿出一本惊动一时的《三重门》。
人间美丽四月天,阳光和煦向暖,日渐强劲的金色光毫,在馈赠于人间一份温暖的同时,姿态和蔼的又不会过暖的灼伤人们的肌肤。风息是温驯的,而且往往因为它是从繁花的山林里吹度过来的一股幽远的馨香,黏附一息温润滑腻的水气,摩挲着你的面庞,环绕在你的周遭,就这单纯的呼吸已是无穷的美妙,直抵五脏六腑的舒适与惬意。空气总是明净的,近谷不生烟,远山不起雾霭,一幅幅美轮美奂的景致,就像画片似的聚焦在瞳孔一览无遗,活色生香的供你怡心受用,供你闲暇鉴赏,供你赋诗作画。
心情对于我们来说是那样重要。健康与美丽,如若没有一份好心情,犹如沙上建塔,水中捞月,一切都无从谈起。心情与我们是形影不离,不,它甚至比影子的追随还要固守的多。光不存在的时候,影子就藏在深深的黑暗中了。只有心情牢牢黏附在胸膛最隐秘的地方,坚定不移地伴随着我们。快乐的人,在黑夜中也会绽出笑容,悲伤的人,即使睡着了,梦中也滴泪。
露打三更,万物俱寂,偶尔一两声蛙鸣穿过荷塘,拖着尾梢的长音刺破夜幕,落入耳膜的一刻,心里也就有了潮湿的味道,疲惫的身体也虚脱的如一树婆娑的柳枝儿,软软的倒置于水岸默视远方。放眼宇宙星空,一个星罗棋布的世界,偌大的星球,如何会留意我孤独的眼神,留意寻觅不到世界温暖的出口怅然若失的孤单。无我,还是浑然忘我?只有雕刻在眉心里的爱知道。揩去残留眼角喜欢招逗的泪水,托起心中依旧纯洁的留白,蘸三两滴朝露,拈几缕花香,丝丝缕缕都黏附着春的气息,是那么暖眼、醇心,也消散人的意志......
有一群鸟帖着夕阳的身边飘过,留下几片轻羽黏附在血红的表面上。也许,痴情的鸟儿想让夕阳长着像他们一样的翅膀吧,飞起来,不至于在黑天到来前沉沦。可鸟儿也不会知道,夕阳本是只来鸟,名字叫金乌,时刻翱翔在天上,永远不会落。
(2)植物的花有香味是为了传宗接代。植物花朵为了引诱昆虫前来授粉,不仅呈现各种艳丽夺目的色彩,还会散发各种迷人的花香。于是引来蜂蝶竞相采蜜,正所谓“蜂争粉蕊蝶分香”。结果,花粉黏附在昆虫的身上,随着昆虫的飞行迁移而四处落户安家了。
电话簿是一个储存朋友的魔盒,假如我遇到困难,就要想他们发出求救信号。一种畏惧孤独的潜意识,像冬眠的虫子蛰伏在心灵的旮旯里。人生一世,消失的是岁月,收获的是朋友。虽然我有时会几天不同任何朋友联络,但我知道自己牢牢地黏附于友谊网络中。
一日,此军赵阳子买一冰淇淋萦绕于嘴边,一手拿拍打球,可每次发球由于单手原因总是失误,他心中大为恼火,仍不停的练习,终于他不知为何把手中大半个冰激凌抛出,“啪”的一声,“球”如烂泥黏附于球台,在场人员都大大叹息:岂不闻浪费可耻之说?可赵阳子仍继续练。这种锲而不舍精神从何来?
这都是藻类的杰作。在寒冷地区,藻类不但分布广,而且种类多,绿色的、红色的、褐色的、黄色的……可谓五颜六色。当红色的藻类遇上大风,便飞向高空,黏附在雪片上,并快速地繁殖,将漫天飘飞的雪花染成了红色。于是,南极有了红雪,北冰洋有了绿雪。